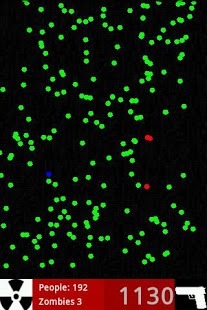

《僵尸感染ZombieInfectionDefender!》僵尸病毒的蔓延,让世界上大多数人都变成了行尸走兽。但是,最后的前哨还有生存的机会,不过仍旧有一个安全漏洞。作为基地司令员,你必须保护所有的人免受僵尸的侵害。你需要采取措施将僵尸消灭,或者使用核武器,或者派遣敢死队队员。游戏有两种模式:生存模式和时间模式。在第一次进攻中,你要好好活着,争取更多的时间来布置战斗决策。在生存模式中,你必须坚持到将对手打死。
xiaohei手游网不仅提供丧尸感染最新手机版的免费下载,而且提供丧尸感染手游的各种攻略和资讯,敬请关注。

激战星球手游 1.16 iOS金币版
熊猫快跑高清版
病毒都市
雷电Ⅲ
打人就打脸
疯狂的部落
战斗陀螺
水果方阵









少年江湖志
天天跑酷HD
钻石费尔托斯特2
E.T.攻击
怪兽多多
疯狂猜价格
斧头哥杰克
刀锋飞行